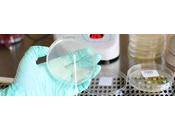
Pyrogen Testing Market Research Report, Product Test Type Application End-User —Global Forecast Till 2030

Cmishivani
MY BLOGS
-
Huge Growth of Big Data in Healthcare Market 2021 | Forecast To 2026 by Opportunities, Demand and Size
https://cmilatestinsights.blogspot.com/
Industry leaders are implementing new ways to manage data, analyze it, and utilize it regularly since the advent of big data. Statistics is one of the most remarkable areas in healthcare where analytics are making a noticeable difference. The market analysis of this product included a range of micro and macroeconomic factors. In addition to providing a thorough overview of big data in healthcare market trends and drivers, this report also evaluates the competitive landscape, companies' productivity, and market share analysis.
A recent report reveals that the big data in healthcare market was worth $ 22,989.33 million in 2020 and eyewitness massive growth will be worth $ 55,404.24 million by 2026, representing a 14.24% CAGR during the forecast period 2021-2026.
Read more @ https://cmilatestinsights.blogspot.com/2021/09/global-big-data-in-healthcare-market.html
LATEST ARTICLES ( 481 )
-
Chatbot Market by Component, Type , Application , Channel Integration, Business...

The global Chatbot market is expected to develop at a compound annual growth rate (CAGR) of 23.5 percent from USD 2.9 billion in 2020 to USD 10.5 billion by... Read more
Posted on 11 March 2022 -
Smart Factory Market Report: by Component , by Connectivity, by Industry...

The Smart Factory Market is expected to develop at a CAGR of 11.7 percent over the next five years. During the projection period of 2018-2023, the market is... Read more
Posted on 11 March 2022 -
Epoxy Resin Market: - Forecast Till 2030

The Epoxy Resin Market is expected to be worth USD 11.78 billion, growing at a CAGR of 7.2 percent over the forecast period (2021 - 2028). , In 2021, the... Read more
Posted on 11 March 2022 -
Cyber Knife Market – Global Industry Insights, Trends, Outlook, and Opportunity...

The Cyber knife is noted for its 0.5 mm to 1.1 mm radiological accuracy, which is utilised to treat malignant cells and brain tumours. Read more
Posted on 11 March 2022 -
Constipation Treatment Market - Global Industry Analysis, Size, Share, Growth,...

During the forecast period of 2017 to 2025, the global market for constipation treatment is expected to grow at a strong CAGR of 7.1 percent. Read more
Posted on 11 March 2022 -
Global Nanoparticles Market - Global Industry Insights, Trends, Outlook, and...

Rise in chronic diseases such as diabetes, cardiovascular disease, and cancer, North America dominated the worldwide nanoparticles market. Read more
Posted on 11 March 2022 -
Electronic Medical Records Market - Global Industry Analysis, Size, Share,...

An electronic medical record is a computerised representation of a patient's paper-based medical information. The goal of these electronic medical records is... Read more
Posted on 10 March 2022 -
Global Xanthan Gum Market Research Report: Analysis and Region - Forecast Till...

The Xanthan gum market is predicted to increase at a 4.5 percent annual pace, with a market value of USD 1.2 billion by 2024. Xanthan gum is a polymer made... Read more
Posted on 10 March 2022 -
Irish Whiskey Market by Type , Pricing , and Sales Channel : Global Opportunity...

The global Irish whiskey market was valued at $4,260.0 million in 2019, and is predicted to grow at a CAGR of 9.2 percent from 2021 to 2027, reaching $7,677.5... Read more
Posted on 10 March 2022 -
Cloud TV Market - Global Industry Analysis, Size, Share, Growth, Trends, and...

Due to developments and increased usage of 5G technology, the cloud TV market is expected to grow at a quick rate throughout the forecast period. Read more
Posted on 10 March 2022 -
Cell Culture Market-Global Industry Analysis, Size, Share, Growth, Trends, and...

The global cell culture market is being driven by the increased prevalence of cancer and cardiovascular illnesses. The biological products derived from cell... Read more
Posted on 10 March 2022 -
Medical Oxygen Concentrators Market Research Report Information by Product,...

The market for medical oxygen concentrators has grown quickly in recent years, with an expected value of USD 4.8 billion by 2026. Read more
Posted on 10 March 2022 -
Matcha Market - Global Industry Analysis, Size, Share, Growth, Trends, and...

The global matcha market is growing due to rising consumer demand for matcha tea, which has numerous health benefits. Matcha tea has a high antioxidant... Read more
Posted on 10 March 2022 -
Pyrogen Testing Market Research Report, by Product , Test Type , Application ,...
The pyrogen testing market was valued at USD 624.2 million in 2016 and is predicted to grow at a CAGR of 9.8 percent to USD 1659.04 by 2030. Read more
Posted on 10 March 2022 -
Shingles Vaccine Market - Global Industry Insights, Trends, Outlook, and...

Global Shingles Vaccine Market DynamicsShingles, commonly known as herpes zoster, is a virus that attacks the brain's cranial nerves. It's caused by the... Read more
Posted on 08 March 2022 -
Oxygen Therapy Market: Global Industry Analysis and Forecast 2016 - 2024

According to the World Health Organization (WHO), total COPD-related mortality are anticipated to increase by 30% in the next decade, necessitating the use of... Read more
Posted on 07 March 2022 -
Malaria Vaccines Market - Global Industry Analysis, Size, Share, Growth,...

Malaria's prevalence in tropical nations has been a source of concern for the entire world, causing millions of fatalities during the last ten years. Read more
Posted on 07 March 2022 -
Micro-molding Materials Market by Material Type, Application and Region -...

The Micro-molding Materials Market is predicted to grow at a CAGR of 11.2 percent between 2021 and 2026, from USD 995 million in 2021 to USD 1,692 million in... Read more
Posted on 03 March 2022 -
Global Study on Sodium Metal Market: MEA Region Expected to Witness Significant...

The sodium metal market should be driven by denim clothing and biodiesel.Rapid economic expansion in developing countries around the world, along with an... Read more
Posted on 03 March 2022 -
Candidiasis Market - Global Industry Analysis, Size, Share, Growth, Trends, and...

The global candidiasis market is primarily driven by an increase in candidiasis instances worldwide, as well as a high rate of candidiasis diagnosis and... Read more
Posted on 03 March 2022
